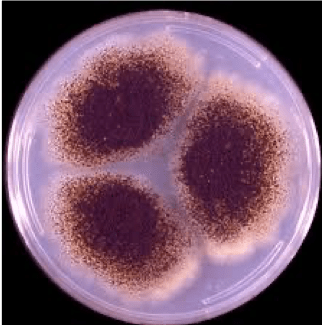
/var/folders/vz/7hcpg2lj35gbwjc69ykmcml40000gp/T/com.microsoft.Word/Content.MSO/BAE553C9.tmp

Cuando he terminado de escribir este artículo me he dado cuenta del “tocho” que me ha salido. Estoy bastante preocupado.
En condiciones normales entiendo que nadie me quiera leer, pero después de este panfleto que estoy largando, lo entenderé mucho más.
Aunque me apetece mucho, no quiero caer en la tentación de centrarme en los luctuosos acontecimientos que estamos viviendo ni a la falta de previsión o dejación de funciones de los irresponsables que tenemos en nuestros distintos estamentos, porque quiero entrar en la parte estructural de nuestros problemas. Lo que nos está sucediendo ahora son hechos que ponen de manifiesto las miserias del establishment tan maravilloso que tenemos, y que son, a mi juicio, solo una parte de lo que nos va a ocurrir si no viramos el rumbo de la nave de forma inmediata.
A pesar de ello, quiero en primer lugar dejar testimonio sentido para todas las personas que han sufrido pérdidas o que están pasando la enfermedad del coronavirus.
Me duele profundamente en el alma ver las noticias donde se hablan de los muertos e infectados con esa frialdad y la subjetividad en la transmisión de la información propias del que quiere a toda costa minimizar los problemas o incluso meritar en una gestión de la crisis que, espero, sea declarada en algún momento como negligente y criminal.
Yo, como afectado directo, sí entiendo su sufrimiento y dejo aquí constancia del respeto y apoyo moral del que soy capaz y, un “chapeau” a los sanitarios que me han atendido, que, como el resto del colectivo, y el resto de la sociedad, está siendo un ejemplo de entrega y abnegación a pesar de los escasos medios con los que contamos.
Para poder llegar a transmitir mi opinión y sentimientos sobre los problemas estructurales que padecemos, me ha parecido mejor articular el documento en diferentes capítulos para permitir, confío, en que, como la urdimbre y la trama, nos ofrezca una pieza al final de su elaboración.
- Un caldo de cultivo
- La Calidad de la democracia en España
- ¿Pactos de la Moncloa?
- Los representantes sociales y la Sociedad Civil
Un caldo de cultivo
En el artículo que compartí con vosotros el pasado 21 de marzo hacía un comparativo entre la experiencia profesional vivida en Banesto (situación históricamente atípica en el mundo financiero español) con las actuaciones del gobierno ya en esta fase de gestión de la crisis y el que básicamente venía a decir:
- Cuando se produjo la crisis, en el banco aterrizó un equipo de profesionales muy capaces, que hicieron posible elaborar y ejecutar un buen y acertado plan de trabajo, mientras que ahora no tenemos nada más que una pandilla de ineptos, una gran parte sin ninguna experiencia profesional y, casi, una parte de ellos, sin experiencia en la vida.
- Destacaba que, en la actualidad, con tantas competencias delegadas, el gobierno en la mayoría de sus ministerios, “no tiene un verdadero control” de la situación. Han ido otorgando competencias, pero sin mantener el control. El ejemplo más reciente ha sido el estrepitoso fracaso del Ministerio de Sanidad al intentar centralizar las compras de material sanitario. No quiero pensar cuántas muertes y cuántas personas contaminadas ha supuesto tan negligente actuación.
Decía, y lo mantengo, que las CCAA se han convertido en auténticos reinos de taifas, con una división político-administrativa de nuestro territorio propias de la época de dominación musulmana tras la disolución del califato cordobés. Afortunadamente todavía no estamos en la situación de desorden y anarquía de antaño, pero estamos camino de ello si no se produce un giro de timón en muchos órdenes.
Decía también, que los políticos actuales solo han vivido época de abundancia y se escudan detrás de la “legitimidad de la política” para hacer lo que más les interesa a ellos Y si, es posible que sea legal pero desde luego ni es ético ni cumple con ninguna de las virtudes cardinales (Prudencia, Justicia, Fortaleza y Templanza). Su credibilidad está bajo mínimos y sin confianza no existe la democracia.
Comprendo la dificultad de afrontar una crisis sanitaria como la que se nos ha venido encima, pero ésta nos ha dejado de manifiesto lo que realmente nos sucede “no tenemos a nadie con liderazgo suficiente ni equipo competente para gestionar” y al final, como anteriormente, en cada CCAA se está gestionando (o incluso contando a los muertos), con el criterio de cada reino de Taifa. Aunque al final, hasta tendremos que estar agradecidos porque si no, todavía estaríamos esperando las primeras compras realizadas por nuestro querido gobierno.
En definitiva, con el artículo del “caldo de cultivo” venía a expresar mi sensación de que tenemos formalmente, un país, una España, pero en la práctica, 17 reinos de taifas, más las ciudades autónomas, en los que, a imagen y semejanza de sus mayores, se encuentran excesivamente ocupados en mantener e incrementar sus cuotas de poder y a crear un clientelismo que les permita mantener su boca cerca de la teta que los sustenta.
Yo se que las cosas son complejas de gestionar y que nada en la vida es perfecto, pero en esta sociedad nuestra, hemos conseguido que, dependiendo de la Comunidad Autonómica en la que te toca vivir por tus circunstancias, tendrás una mejor o peor educación para tus hijos, una mejor o peor atención sanitaria, un nivel de impuestos mayor o menor, una administración más o menos ágil,… Y, todo esto, multipliquémoslo por muchas veces cuando hablemos de aquellos aspectos donde tienen competencia los Ayuntamientos. Y se les llena la boca diciendo que quieren una España más igualitaria.
Estas permanentes transferencias, fruto en casi todos los casos de trueques electorales en beneficio de partidos políticos, que no de la gestión de los territorios, han ido produciendo un Estado débil incapaz de gestionar divisiones políticas mal resueltas, y, ni mucho menos, abordar cuestiones que requieren de una planificación y consenso de largo plazo para la ciudadanía. Están todos instalados en el corto plazo (a golpe de telediario) e improvisando permanentemente.
La Calidad de la democracia en España
Tanto si analizamos los estudios por el Instituto Internacional para la Democracia y Asistencia Electoral (IDEA, organización intergubernamental que apoya la democracia sostenible en todo el mundo), como el que elabora la Fundación Alternativas (que otorga un 5,8 en una escala de cero a diez) o bien The Economist, en todos los casos, los expertos coinciden en que España se puede situar entre las 20 primeras democracias consolidadas del mundo.
Yo también creo consolidados lo que miden los principales indicadores que utilizan, procesos electoral y pluralismo, funcionamiento del Gobierno, participación política, cultura política democrática y libertades civiles y que ahora están arraigadas y forman parte de nuestro ADN.
Pero nuestra opinión pública no tiene el mismo sentimiento que el de los expertos, ya que según una encuesta de Metroscopia publicada antes de la repetición de elecciones, solo el 40% de los españoles declaraba estar contento con la democracia española.

La inmensa mayoría de los españoles (87/%) consideran que el régimen democrático es sin duda preferible a cualquier otro sistema.
El problema es su funcionamiento: dos de cada tres consideran que está funcionando mal. Y funciona mal porque los partidos han generado una clara decepción ciudadana y generado no solo una desconexión entre instituciones y ciudadanos sino un país donde el orgullo nacional se ha ido debilitando en el tiempo y en que se ha instalado la sensación de que el estado del bienestar es algo que nos viene dado como el maná del cielo.
Y en este sentido, sobre la “calidad de la democracia”, los expertos no tienen en cuenta otros problemas reales de nuestra sociedad, como el desempleo, la educación, la desigualdad, el acceso a servicios públicos de calidad, la igualdad de oportunidades o, en general, el bienestar social, y, ni mucho menos, la resolución pendiente de los problemas estructurales españoles. Todo ello son factores clave para entender la verdadera calidad de una democracia.
Obviamente el Doctor Sánchez corre a ponerse medallas cada vez que hay algún indicador de este tipo con resultados positivos, pero no presta ninguna atención al sentir de su ciudadanía y ni tampoco husmea en las razones que llevan a que, en la clasificación de ‘The Economist’, la variable peor valorada (muy por debajo de la media) sea la función de Gobierno.
Todos estos señores que tenemos como políticos, no parecen haber entendido que la democracia no es gobernar en nombre del pueblo, sino hacerlo respetando las voluntades reales del pueblo. No hay nada tan irresistible como un poder tiránico que manda en nombre del pueblo.
No obstante, que la democracia decaiga no significa que se quiebre de forma inmediata, pero sí se va taladrando, como hacen los insectos con los geranios, hasta que se seca, lo cual provoca que cada vez sus resultados se vuelven más decepcionantes para más gente, los ciudadanos se vuelven más escépticos y menos participativos, el control de los Gobiernos se vuelve más costoso, el desarrollo se ralentiza… porque si nos volvemos descreídos el control del poder político será cada vez más difícil y la democracia deja de ser una promesa interesante para muchos y eso provoca la aparición de grupos cada vez más radicales, como está sucediendo en Europa, por cierto.
En mi vida profesional he tenido la oportunidad de conocer empresas que tenían “perfectamente instalados” todos los mecanismos de gestión y de control. Excelentes comités de Dirección, auditorías independientes, Consejeros formados y con decisión autónoma, modelos de control,…… Pero que en el fondo estaban instalados “formalmente” para cumplimiento de la normativa, pero con un funcionamiento real del ordeno y mando del que se sienta en la poltrona. Esto mismo es lo que nos está pasando en nuestro País, con una democracia “formalmente instalada” pero que no es útil ni aporta la suficiente felicidad a sus ciudadanos ni al desarrollo económico o social.
Considero que la ideología es absolutamente necesaria y sana en una democracia, pero la gestión de los responsables, orientados realmente a los ciudadanos, es fundamental, no todo es ideología. Sucede lo que en muchas empresas grandes que dicen que “el cliente es el centro de su atención”, cuando realmente están repletos de directivos que no luchan más que porque la conservación de sus puestos y que, en estado permanente de complacencia, se instalan en la comodidad sin permitir la más mínima crítica sobre la gestión que realizan.
Y debemos añadir otro factor esencial para entender la situación actual. Si buscamos el término corrupción en la R.A.E., nos dice:
4. f. En las organizaciones, especialmente en las públicas, práctica consistente en la utilización de las funciones y medios de aquellas en provecho, económico o de otra índole de sus gestores.

En un sentido amplio, corrupto no es solo el político que se lleva el dinero (para él o su partido), sino también el que coloca a amiguetes o afines en puestos de responsabilidad sin que tengan preparación para ello. Corrupto sería el político que diseña políticas o realiza actuaciones que favorecen a su partido y no a los ciudadanos, corrupto es aquél que utiliza los medios de comunicación en beneficio propio o de su partido para limitar la libertad de expresión, para realizar adoctrinamiento o atacar a sus competidores. Corrupto seria también el político que acepta un puesto de responsabilidad sin tener la preparación o experiencia necesaria para ejercerlo.
Con esta visión amplia, considero que tenemos un nivel de corruptela muy extendido entre la clase política actualmente y que, al estar tan generalizada, es bastante difícil establecer mecanismos adecuados de rendición de cuentas porque entre ellos tienen mucho interés en evitar que haya castigos efectivos.
Uno de las cosas que nos harían mejorar el nivel de corrupción que tenemos, sería el de mejorar la selección de la clase política, a quien hoy:
- No se les exige ningún requisito de formación para acceder a puestos de parlamentarios, senadores, concejales, ni, por supuesto, para Presidente de Gobierno
- Se les permite mentir. ¿en cuantas mentiras se ha pillado a nuestro presidente del gobierno actual y se mantiene en el puesto?
- Se les permite hacer una lista de promesas electorales e incumplirlas todas. Las hemerotecas son muy malas, señores políticos.
Y, de forma simultánea, tendríamos que mejorar los métodos de rendición de cuentas y los mecanismos de revisión de la actuación antes de que, en 4 años de mandato, hayan generado la ruina del país.
¿Y todavía se sorprenden que en los indicadores de calidad democrática salga que en España los niveles de desconfianza social y hacia las instituciones, y de ineficacia política de la ciudadanía son particularmente altos?
¿Pactos de la Moncloa?
En los Pactos de la Moncloa, todas las fuerzas políticas y territoriales se concertaron para establecer unas bases sobre las que modernizar el país. La radiografía de aquella España de 1977 presentaba, en el terreno económico, un cuadro clínico explosivo y con de los graves problemas estructurales de la economía española, que se ha instalado a lo largo de los 40 años, el desempleo.


Si echamos un vistazo a las personas que formaban parte de nuestros inicios de democracia y los de ahora, y tenemos la curiosidad de analizar sus trayectorias profesionales, veremos que nuestros primeros políticos de la democracia (de muy diversas o incluso radicales ideologías) ganan por goleada en cuanto a experiencia y formación a los políticos de ahora.
Por otro lado, hay que destacar que al inicio de la democracia, había un objetivo común instalado en la cabeza y en la consciencia de todos los participantes (más bien de casi todos), que era el de conseguir una serie de libertades importantes para nuestra sociedad, cosa que en el contexto actual, en el que casi todos se han criado en ese estado de libertades y el posterior estado del bienestar que se consiguió, lo dan como natural y “juegan” a otras cosas sin aportar el esfuerzo necesario para mantener lo conseguido.
Pero hay otro aspecto diferencial, y a mi juicio peligroso, como decía Luis del Valls hace unos días: en esa época, en la que no olvidemos que el ejército no tenía muchas ganas de dar el salto a la democracia, todos teníamos miedo a no conseguirlo, lo cual aportaba las dosis de sensatez necesarias para ceder en lo necesario hasta alcanzar los consensos.
En los políticos actuales, ese miedo no se tiene y eso es un riesgo importante porque lo que no se cuida, se termina estropeando y muriendo.

En todo caso, es difícil mejorar cosas cuando no hay actitud para ello, y las actitudes que está demostrando este gobierno son más propias de un gobierno totalitario que democrático.
A pesar de que a estos dirigentes les gusta utilizar términos bélicos, creo que no se han dado cuenta que la guerra es muy parecida a lo que nos está ocurriendo. Hemos sido atacados (por un virus), hemos tenido que sacar a los militares a la calle, tenemos millares de muertos y todo esto a dejar nuestra economía, como ha dicho Luis de Guindos, en niveles que podrían llegar a ser como los posteriores a nuestra guerra civil.
En este escenario, estos señores se permiten el lujo de seguir igual que antes, siendo prepotentes, no contando con el resto de fuerzas políticas del país, no consultando a sus mayores con más experiencia (como ha reconocido recientemente el exministro Corcuera). Todo lo contrario, siguen sacando pecho por una gestión, que más bien podría calificarse de negligente, e intentando sacar provecho de las facultades del estado de alarma para poner en marcha medidas que solo son necesarias para su ideario político.
Se han hecho con el control de los principales medios de comunicación del país y filtran/censuran la información a los ciudadanos y los utilizan como plataforma para atacar a otras formaciones políticas de forma permanente. ¿y estos se quejaban (aunque casi ninguno lo vivió) de las políticas franquistas?
Son unos perfectos irresponsables, no se están dando cuenta que se han encontrado con el edificio de la democracia construido, pero afectado por aluminosis y que ellos lo están incrementando.
En definitiva, están a lo suyo, a conseguir más parcelas de poder, a sus corruptelas, con su soberbia y su indignidad y, como no gestionan realmente el país, hacen bueno el pensamiento de Ortega y Gasset:

De verdad que deseo que fueran capaces de ver la luz y que sus entendederas se alarguen lo suficiente para comprender que es el momento de hacer un gobierno de coalición que de verdad aborde los problemas de los ciudadanos, pero mucho me temo, por lo que están demostrando, que no tienen talento ni talante para ello.
Y, en todo caso, si lo hicieran, que no hagan más operaciones de maquillaje y tengan en cuenta que de lo que se trata es de solucionar muchos de los problemas estructurales que arrastramos desde hace mucho tiempo:
- Productividad, indicador de progreso y de mejora en los estándares de vida. Entre 2001 y 2016 tenemos caídas de entre el 5% y el 10%, estando a la cola de los países más avanzados de la UE. Eso si, tranquiliza que estamos mejor que Rumanía o Bulgaria.
De hecho, la falta de crecimiento de productividad es la causa principal de que España no haya convergido desde mediados de los años 70 del siglo pasado al nivel de renta de los países del norte de Europa.
- Serio problema de cuentas públicas en el corto y en el largo plazo. En el corto plazo, el déficit estructural de las administraciones públicas, es decir, el déficit descontado el efecto del ciclo económico, ronda el 2,5% del PIB, lo cual nos sitúa en un estado de debilidad absoluta para afrontar el nuevo “sunami” económico que se nos viene encina. Y en el largo plazo nos enfrentamos a un problema de pensiones y asistencial, derivado de nuestra situación demográfica, que nadie tiene narices a abordar y no solo por la sostenibilidad del sistema de pensiones, sino por el incremento del gasto sanitario en la medida en que crece la expectativa de vida.
España registra el mayor déficit estructural de la zona euro, lo cual dificulta enormemente la reducción de la deuda con respecto al PIB, Por lo que apenas tenemos margen fiscal y por lo que el gasto subirá más y la recaudación tenderá a bajar, por lo que nuestro agujero presupuestario volverá a crecer de forma intensa.
- Mercado de trabajo ineficiente, siendo, por su nivel de desempleo y de temporalidad, una «anomalía internacional» y, seguramente no sea achacable tanto al “modelo productivo”, sino a:
- Políticas activas de empleo poco eficientes
- Cotizaciones sociales que, superiores a la media europea, encarecen la contratación
- Una negociación colectiva centralizada, con efecto «normativo» de los convenios (que los hace obligatorios para empresas y trabajadores que no participaron en su negociación).
- Escasa movilidad geográfica de los desempleados, que explica las grandes diferencias regionales de las tasas de desempleo.
- Y un sangrante «paro subsidiado» en zonas rurales que fomenta poco las ganas de producir.
.Un sistema público caro y espeso con escasa eficacia en el uso de los recursos que se le asignan y con problemas del tipo:
- Corrupción y fraude en el uso de fondos públicos;
- Una regulación de la actividad económica que impone costes excesivos a los empresarios;
- Confusión la gestión pública en régimen de monopolio por la Administración de un servicio público -sin competencia entre posibles gestores- con la universalidad de las prestaciones.
- Raquitismo empresarial, con una media de 4,6 trabajadores, frente a los 12 de Alemania. Ese exiguo tamaño limita su capacidad para internacionalizarse y competir. Y todo esto, viene motivado en gran parte por la legislación y prácticas administrativas que lo fomentan indirectamente:
- Imposición de especiales obligaciones a las empresas con más de 50 trabajadores (por ejemplo, creación de un comité de empresa);
- Lenta y burocráticas gestiones en las autorizaciones para la creación de empresas.
- Falta de mecanismos que financien el crecimiento de las empresas.

Si, es imprescindible que la modernidad que nos gobierna, abandone ese pensamiento débil que les instala permanentemente en lo coyuntural, Es decir, atender el último dato para particular un discurso, casi siempre interesado y alejado del rigor que no solo lleva a la confusión sino que, además, impide abordar los temas estructurales que necesitan, además de un adecuado consenso, una maduración de muchos años:
- Educación, Con una tasa de fracaso escolar sin parangón (20% en España frente a 2% en Corea, por ejemplo).
- Sanidad, con un funcionamiento disperso entre las diferentes CCAA
- Justicia, con un sistema lento y poco eficiente.
- Energía, Ante el cierre de centrales nuclares y térmicas, teniendo que abastecer a una población que cada año consume más energía por persona, y sin decisión sobre el modelo alternativo y el dinero necesario.
- Agua, en un país que se va desertificando progresivamente y no contamos con una verdadera política de embalses o trasvases y en el que se espera que para el 2030, aproximadamente un 65% de la población tenga problemas de abastecimiento.
- …….
Ante la gravísima crisis sanitaria que estamos viviendo, la nueva crisis ya sobre la mesa, y la consiguiente amenaza de descomposición de nuestros grandes logros institucionales, económicos y sociales, es extremadamente urgente que el PSOE siente la cabeza y se junte con el PP y C’s para tratar de sacar adelante nuestro país de la mejor manera posible y con un gobierno que incorpore perfiles profesionales intachables, que en España sobran.
Yo soy de los que considera imprescindible un gran pacto de estado en estos momentos, pero de fondo, no de forma.
Los Representantes Sociales y la Sociedad Civil
Ya hemos visto el panorama que tenemos. ¿y frente a esto qué?, pues yo creo que, de momento y desgraciadamente, NADA.
Se tiende a denominar y a incluir con categoría de Agentes Sociales a una serie de organismos, agrupados en distintas tipologías: Organizaciones Empresariales (CEOE y CEPYME), Organizaciones Sindicales (UGT, CC.OO, (estos dos con más del 70% de presencia en los comités de empresas- USO, ELA y CIG), Otras Organizaciones, que representan una amplia diversidad de asociaciones, Fundaciones, Observatorios, y diversos ámbitos de la Administración entre los que cabe destacar la Federación Española de Municipios y Provincia (FEMP).
Y, por otro lado, tenemos un sin fin de las autodenominadas ONG’s, organizaciones subvencionadas e influidas por partidos políticos de todas las ideologías.
Yo en mis tiempos mozos fui un activista en el mundo sindical y puedo dar fe que los sindicatos de entonces, tanto en cuanto a su filosofía como a su funcionamiento, nada tiene que ver con los de hoy, a los cuales encuentro absolutamente deslegitimados social y políticamente porque no tienen base de afiliación o militancia de sus miembros para representar ni a los trabajadores ni a la sociedad.
El sindicalismo español ha convertido parte de la acción sindical en empresas de servicios a la búsqueda de subvenciones y mecanismos de financiación (cuando no de corruptelas) para mantener sus enormes estructuras burocráticas y se han convertido en instrumentos cómodos para los gobiernos, a cambio del precio adecuado, claro.

Adicionalmente, a lo largo del tiempo, además de los sindicatos tradicionales, los regionalistas y los sectoriales, se ha ido creando un entramado de asociaciones: ONG’s, asociaciones de consumidores, cámaras agrarias, cámaras de comercios,… que se suponen que ostentan la “representación social” pero que son solo organizaciones abrazadas a la ubre que les da de mamar cada legislatura.
Por tanto, la pregunta es ¿existe realmente una sociedad civil en España.? Si por sociedad civil entendemos una sociedad adulta, consciente de sus derechos y de sus responsabilidades, bcapaz de poner límites a este intervencionismo de las administraciones, la respuesta es NO.
Por razones profesionales, tuve la oportunidad de disfrutar de algunas charlas de Antonio Garrigues Walker, que opinaba que el problema de la sociedad civil está en que no habla, no levanta la voz, no dice nada. Cada uno de nosotros no estamos haciendo lo que tenemos que hacer y que la clave está en asumir nuestra propia responsabilidad.
Y estoy de acuerdo, empezando por mí, que la sociedad civil no es que esté dormida, es que no está interesada y por tanto no hace nada. Tras pasar los primeros años de democracia, en la medida en que la consolidación de la misma y el estado del bienestar ha ido dando sus frutos, ha ido decayendo el interés de la participación en las cuestiones políticas y hemos ido envejeciendo preocupándonos cada uno de lo nuestro. En mi caso también.
Las nuevas generaciones, “que se lo han encontrado todo hecho”, no han sentido las inquietudes que de forma permanente bullían antaño en nuestras universidades.
Los acuerdos y cambios que hay que provocar son de mucho calado, y en la actualidad, no veo ni talla ni interés por parte de los políticos en cambiar nada, entre otras cosas porque iría en contra de sus propios intereses.
En este sentido, lo único que veo posible que esté en nuestra mano, es que volvamos a ser políticamente activos y ser mucho más participativos en todo, de tal forma que, con nuestras protestas y propuestas, se pueda escuchar la voz de una sociedad civil que está harta.
Yo me he declarado de nuevo “políticamente activo” y voy a participar mucho más y quiero hablar con los demás, no para convencerles de que piensen de otra manera, sino para que sean exigentes con los políticos que nos conducen, aunque sean de su mismo color.
Como dice Julio Anguita, que precisamente no es sospechoso de ser muy de derechas, hay que “medir a las fuerzas políticas por lo que hacen” y “hay que votar al honrado, no al ladrón”.
Zapatero negó la anterior crisis económica, Rajoy negó la crisis catalana y Sánchez la actual crisis sanitaria, y el resultado en cada caso, ha sido que los ciudadanos hemos pagado caro sus errores. Ahora con la vida de más personas de las que se debería y, encima, una parte del gobierno, con sus televisiones al frente, está considerando que ésta es una muy buena ocasión para desmontar nuestro edificio constitucional y de paso a quien tan bien lo corona, S.M. El Rey.

El pueblo español ha sido siembre combativo cuando ha tenido que hacerlo. Iberia fue el territorio que más siglos les costó conquistar a los romanos, pudimos expulsar a los Árabes de nuestros territorios, montamos el mayor imperio del mundo con los Reyes Católicos y vencimos, con pocos medios y mucho valor, al mayor ejército del mundo entonces, a Napoleón.
Pero igual que tenemos la virtud de estar unidos y sacar las garras en tiempos difíciles, también la historia nos enseña que tenemos el defecto de entregar el gobierno a patanes e ineptos que han venido a servirse de nosotros, no a servirnos.
Pues ahora es otro de esos momentos difíciles para España, y, seamos de un color u otro, hemos de demostrar que la ciudadanía no está dispuesta a soportar más la gestión de incompetentes y corruptos.

El tiempo corre en nuestra contra y por tanto es el momento de actuar para el ciudadano para, al menos, tener la conciencia tranquila de haber peleado con la única arma legítima que nos queda, la voz. Yo ya estoy ahí.
Ya veo que sigues peleón. ¡ Arriba los corazones !!. Bien venido al mundo de los trabajadores. No parece que te falte el aire. Sigo sin saber como se opina en el mismo sitio ese. Luego lo intento otra vez- Abrazos,
__________________________________ José Corral Lope http://www.supervivenciayaltruismo.com http://www.survivalandaltruism.org
Me gustaMe gusta
No puedo estar más de acuerdo con este artículo. Espero que esto sea la opinión de más personas para que se exprese críticamente esta situación que se está viviendo y se puedan encontrar las soluciones necesarias. No todas se tienen que inventar de nuevo, o ya se han practicado en otros países o en el pasado. Solo hay que querer!.
Me gustaMe gusta
Me alegro de verte restablecido física e intelectualmente, no tengo más remedio que manifestar mi más completa simbiosis con cuanto expones.
Espero que la astenia involuntaria que caprichosamente produce mi organismo, pero que venzo con facilidad en cualquier actividad presencial, me permita contrastar opiniones tan acertadas.
Un saludo
Me gustaMe gusta
Pepe muy bueno, espero que vayas mejorando tu eres un corredor de fondo y no hay obsaculos, no te has enrollado demasiado, esta perfecto para la salud mental. Mándame p.f. el articulo tuyo que haces mención del día 21-3,
Un fuerte abrazo.
Me gustaMe gusta
Leído lo del coronavirus. Gracias por lo que me toca como ancianito. Te ha quedado muy bien. Y no te ha faltado aire. Sigue. Un abrazo __________________________________ José Corral Lope http://www.supervivenciayaltruismo.com http://www.survivalandaltruism.org
El lun., 13 abr. 2020 a las 11:19, José Corral () escribió:
> Ya veo que sigues peleón. ¡ Arriba los corazones !!. > Bien venido al mundo de los trabajadores. No parece que te falte el aire. > Sigo sin saber como se opina en el mismo sitio ese. Luego lo intento otra > vez- > Abrazos, > > > __________________________________ > José Corral Lope > http://www.supervivenciayaltruismo.com > http://www.survivalandaltruism.org > > > El lun., 13 abr. 2020 a las 9:49, Políticamente Incorrecto (<
Me gustaMe gusta